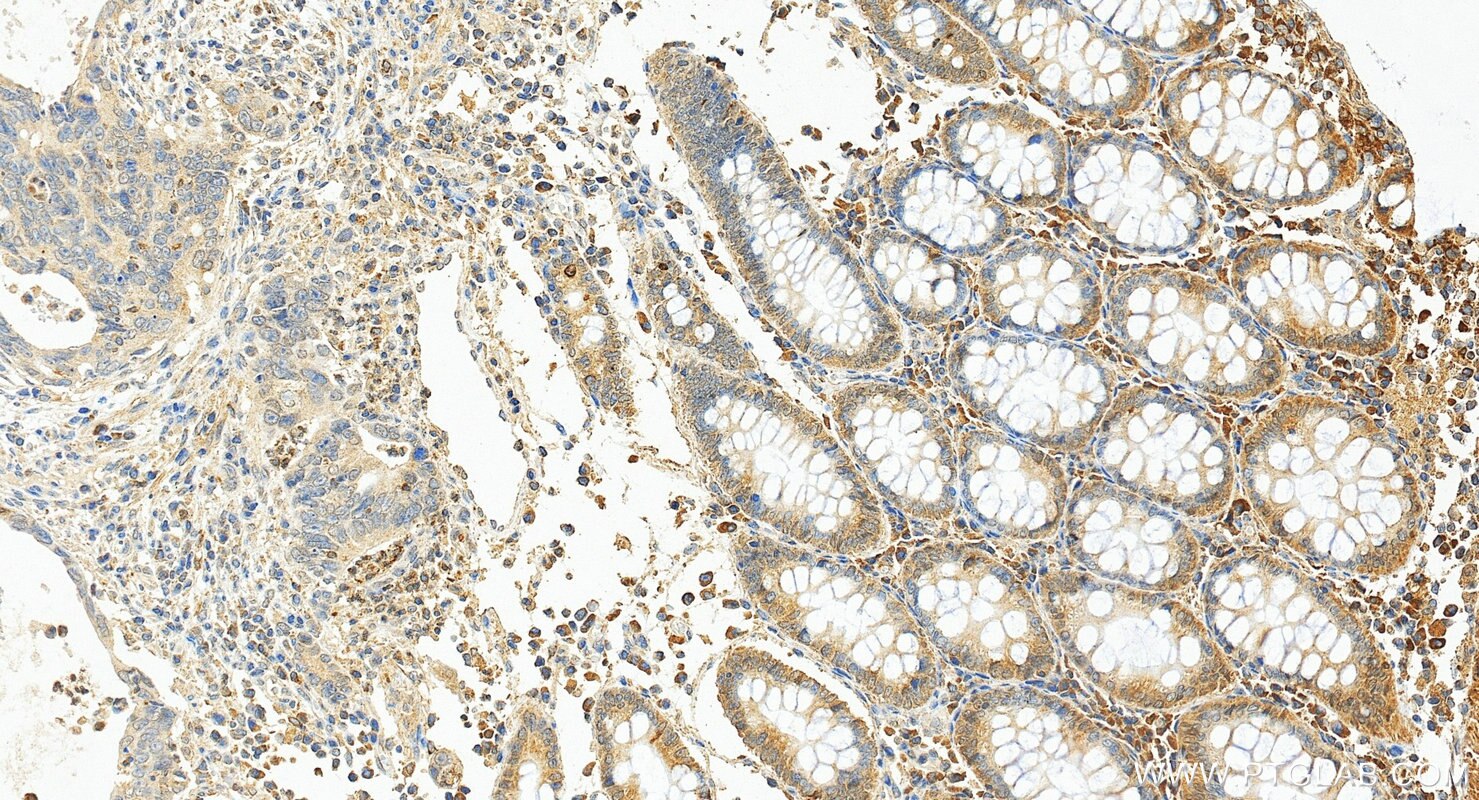
Immunohistochemistry (IHC) staining of human colon cancer tissue using SERCA3 Monoclonal antibody (68287-1-Ig)
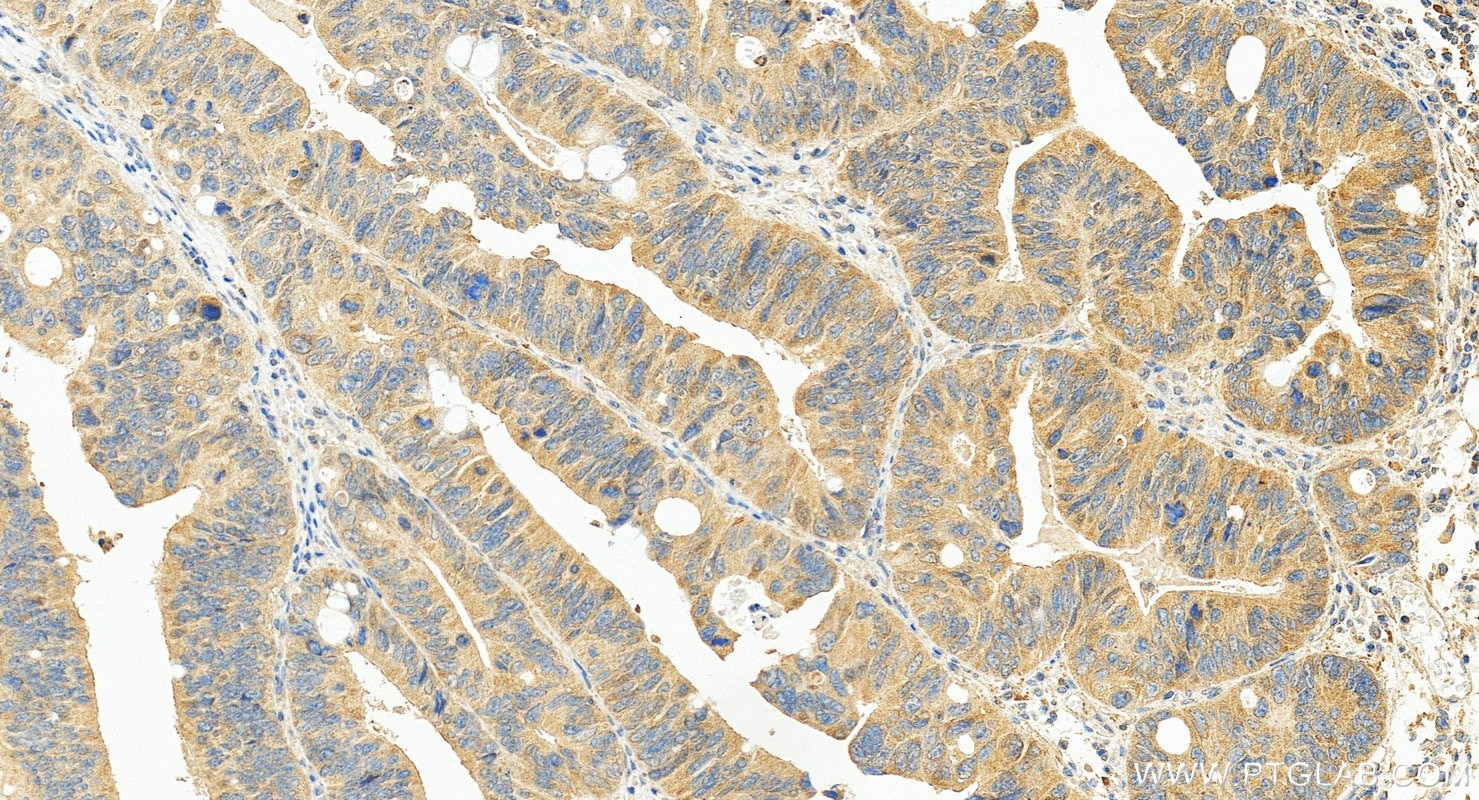
Immunohistochemistry (IHC) staining of human colon cancer tissue using SERCA3 Monoclonal antibody (68287-1-Ig)

Validation Data Gallery
Tested Applications
Recommended dilution
| Application | Dilution |
|---|---|
| It is recommended that this reagent should be titrated in each testing system to obtain optimal results. | |
Product Information
68287-1-PBS targets SERCA3 in WB, IHC, IF/ICC, Indirect ELISA applications and shows reactivity with human, mouse, rat samples.
| Tested Reactivity | human, mouse, rat |
| Host / Isotype | Mouse / IgG1 |
| Class | Monoclonal |
| Type | Antibody |
| Immunogen |
CatNo: Ag4527 Product name: Recombinant human ATP2A3 protein Source: e coli.-derived, PGEX-4T Tag: GST Domain: 323-999 aa of BC035729 Sequence: TRRMARKNAIVRSLPSVETLGCTSVICSDKTGTLTTNQMSVCRMFVVAEADAGSCLLHEFTISGTTYTPEGEVRQGDQPVRCGQFDGLVELATICALCNDSALDYNEAKGVYEKVGEATETALTCLVEKMNVFDTDLQALSRVERAGACNTVIKQLMRKEFTLEFSRDRKSMSVYCTPTRPHPTGQGSKMFVKGAPESVIERCSSVRVGSRTAPLTPTSREQILAKIRDWGSGSDTLRCLALATRDAPPRKEDMELDDCSKFVQYETDLTFVGCVGMLDPPRPEVAACITRCYQAGIRVVMITGDNKGTAVAICRRLGIFGDTEDVAGKAYTGREFDDLSPEQQRQACRTARCFARVEPAHKSRIVENLQSFNEITAMTGDGVNDAPALKKAEIGIAMGSGTAVAKSAAEMVLSDDNFASIVAAVEEGRAIYSNMKQFIRYLISSNVGEVVCIFLTAILGLPEALIPVQLLWVNLVTDGLPATALGFNPPDLDIMEKLPRSPREALISGWLFFRYLAIGVYVGLATVAAATWWFVYDAEGPHINFYQLRNFLKCSEDNPLFAGIDCEVFESRFPTTMALSVLVTIEMCNALNSVSENQSLLRMPPWMNPWLLVAVAMSMALHFLILLVPPLPLIFQVTPLSGRQWVVVLQISLPVILLDEALKYLSRNHMHEEMSQK 相同性解析による交差性が予測される生物種 |
| Full Name | ATPase, Ca++ transporting, ubiquitous |
| Calculated molecular weight | 1043 aa, 114 kDa |
| Observed molecular weight | 97-110 kDa |
| GenBank accession number | BC035729 |
| Gene Symbol | SERCA3 |
| Gene ID (NCBI) | 489 |
| RRID | AB_2935368 |
| Conjugate | Unconjugated |
| Form | |
| Form | Liquid |
| Purification Method | Protein G purification |
| UNIPROT ID | Q93084 |
| Storage Buffer | PBS only{{ptg:BufferTemp}}7.3 |
| Storage Conditions | Store at -80°C. |
Background Information
The SERCA, which pumps cytosolic Ca2+ into the ER, is an imperative maintainer of ER Ca2+ homeostasis. The mammalian SERCA family is comprised of three tissue-specific members, SERCA1-3. SERCA3 is present in endothelial and epithelial cells of various tissues. SERCA3 helps regulate intracellular Ca2+, which is critical for maintaining normal INS secretion and is closely linked to metabolism, neuronal plasticity, gene transcription, cell growth, differentiation, apoptosis, protein folding and carcinogenesis. Several isoforms of SERCA3 exist due to the alternative splicing.